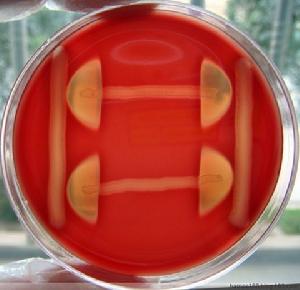
CAMP實驗

原理
B群鏈球菌能產生CAMP因子,可促進金黃色葡萄球菌β-溶血素活性。在血瓊脂平板上2種細菌交界處溶血能力增強,形成箭頭狀的溶血區。
操作
在血瓊脂平板上以金黃色葡萄球菌ATCC25923作一橫線接種,垂直處用被檢菌接種一條線,2線不能相交且相距0.5-1cm。
35℃孵育18~24h後觀察結果。
結果
2接種線之間出現箭頭狀的溶血區為陽性。
 CAMP實驗
CAMP實驗
CAMP實驗是協助對B群鏈球菌的初步鑑定。
B群鏈球菌能產生CAMP因子,可促進金黃色葡萄球菌β-溶血素活性。在血瓊脂平板上2種細菌交界處溶血能力增強,形成箭頭狀的溶血區。
在血瓊脂平板上以金黃色葡萄球菌ATCC25923作一橫線接種,垂直處用被檢菌接種一條線,2線不能相交且相距0.5-1cm。
35℃孵育18~24h後觀察結果。
2接種線之間出現箭頭狀的溶血區為陽性。
CAMP實驗
CAMP實驗二、實驗方法 二、實驗方法 二、實驗方法
《醫學微生物實驗技術》化學工業出版社2006年出版,以醫學微生物學為核心、兼論基礎微生物學及其他相關微生物實驗技術的指南。
簡介 目錄:《細胞免疫學實驗研究方法》是由孫黎飛所著的一本書籍之一,於2009年人民軍醫出版社出版。
作者簡介 圖書目錄與單方豬苓提取物對癌細胞的增殖均有抑制效果,證明細胞內cAMP水平升高與細胞質內cAMP磷酸二酯酶受到抑制有關;發現正常細胞和腫瘤細胞的細胞周期...聽課、實驗操作和課後作業,都非常認真。還常到圖書館博覽群書,蒐集中外文...
人物生平 主要論著 科學成就 教育貢獻的,例如當細胞內環腺苷酸(cAMP)水平增高,細胞密度增加時,可阻止細胞...
概述 細胞周期測定 周期詳解 影響因素 細胞分類概述大黃 出自《神農本草經》 。陶弘景:大黃,今采益州北部汶山及西山者,雖非河西、隴西,好者猶作紫地錦色,味甚苦澀,色至濃黑,西...
概述 生境分布 藥品簡述 用藥禁忌 臨床套用概述大黃 出自《神農本草經》 。陶弘景:大黃,今采益州北部汶山及西山者,雖非河西、隴西,好者猶作紫地錦色,味甚苦澀,色至濃黑,西...
概述 生境分布 藥品簡述 用藥禁忌 臨床套用的吸收、排泄和分布:以人體和動物(家兔和小鼠)實驗,1次po和im、iv大黃蒽醌衍生物,觀察在體內的吸收、排泄和分布的情況。實驗結果表明,蒽醌衍生物...的大黃素體外代謝實驗,檢出主要代謝產物為1、、2、、3、、4、和5...
基本信息 植物形態 藥代動力學 藥理作用 商品化學成分